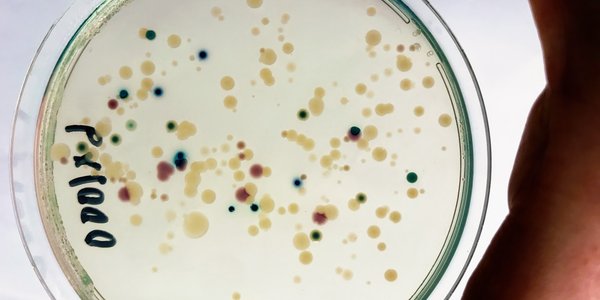
vibrio

2020
Resultat: (337) Viser 151 - 180

Har risikovurdert lakselus
06.07.2020

Makrelltoktet går – følg det på nett
03.07.2020

Han skal leie digitaliseringsarbeidet ved HI
02.07.2020

kronikk
Vi er klare – sats på tare!
01.07.2020
Tilrår lågare seikvote i Nordsjøen
30.06.2020

Har kartlagt miljøgifter i tre nye fiskeslag
26.06.2020

Dårligere egg når laksen gyter om sommeren
25.06.2020

Modellar viser forskarane kvar korallane er
23.06.2020

Fredet hummer får større klør
18.06.2020

Torsk kan forebygge fedme
17.06.2020

Fangstprøvelotteriet kan bli obligatorisk
17.06.2020